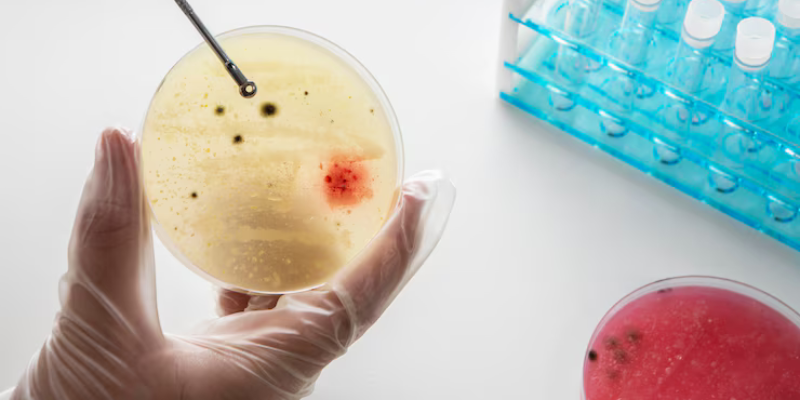

Urology Treatment
- Home
- Urology Treatment
Specialized Urology Care for Kidney, Bladder & Urinary Health
Our urology department offers expert diagnosis and treatment for a wide range of urinary tract and male reproductive system disorders. Using modern diagnostic tools and minimally invasive techniques, our skilled urologists provide personalized care for conditions such as kidney stones, prostate problems, urinary infections, and urological cancers. We are committed to improving your quality of life through precise treatment, privacy, and compassionate care.
At our hospital, the Urology Department is dedicated to the diagnosis, treatment, and management of conditions affecting the urinary tract in both men and women, as well as disorders of the male reproductive system. We offer a full spectrum of urological care using the most advanced technology, including minimally invasive surgery, endoscopic procedures, and laser treatments—ensuring precision, safety, and faster recovery.

Kidney Stone Management
Treatments include:
- Ultrasound and CT-based diagnosis
- Extracorporeal Shock Wave Lithotripsy (ESWL)
- Ureteroscopy and laser lithotripsy
- Dietary counseling and metabolic evaluation

Urinary Tract Infections (UTIs)
Treatments include:
- Urine culture and sensitivity testing
- Antibiotic therapy
- Evaluation for underlying causes (e.g., stones, anatomical issues)
- Preventive care and hygiene guidance

Prostate Disorders (BPH, Prostatitis)
Treatments include:
- PSA testing and digital rectal exam
- Medication for benign prostatic hyperplasia (BPH)
- Minimally invasive surgery (TURP)
- Prostate cancer screening and biopsy

Male Infertility & Sexual Health
Treatments include:
- Semen analysis and hormone testing
- Treatment for erectile dysfunction and premature ejaculation
- Varicocele repair and sperm retrieval techniques
- Counseling and assisted reproductive techniques (ART) referrals
Urinary Incontinence & Bladder Disorders
Treatments include:
- Bladder function tests (urodynamics)
- Pelvic floor therapy
- Medication and Botox for overactive bladder
- Sling surgery for stress incontinence

Urological Cancer Diagnosis & Treatment
Treatments include:
- Imaging and biopsy diagnostics
- Post-surgical monitoring and follow-up
- Multidisciplinary cancer care planning

